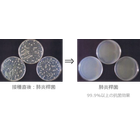
021410.png

抗菌・抗ウイルスコーティングで施設の接触感染対策|サンテクガード
サンテクガードは、施設内のさまざまな接触面に施工できる抗菌・抗ウイルス表面処理コーティングです。 ドアノブ、手すり、テーブル、設備機器などの接触頻度の高い箇所に施工することで、衛生環境の維持に貢献します。 医療施設や介護施設だけでなく、学校、公共施設、商業施設など多くの人が利用する環境での感染対策として活用されています。 透明コーティングのため外観を変えることなく施工が可能で、日常的な衛生管理の補助として利用することができます。 噴霧施工だけで空間を保護 大規模な改修工事や設備変更を行うことなく、既存の壁面・天井・接触面に噴霧施工するだけで空間全体の衛生環境を向上させます。 ○ 移動不要 什器や大型備品の大幅な移動を必要とせず施工可能 ○ 大規模工事不要 内装の張替えや改修を伴わないためコストを抑制 ○ 短時間施工 短時間での施工が可能なため、夜間・休業時間内にも対応 ○ 施設運用を止めない 営業・運営への影響を最小限に抑えながら導入可能
この製品へのお問い合わせ
基本情報
【施工対象】 ドアノブ / 手すり / テーブル / カウンター / 壁面 / 設備機器 【施工環境】 医療施設 / 介護施設 / 学校 / 商業施設 / 公共施設 / オフィス 【特長】 透明コーティング 抗菌・抗ウイルス表面処理 接触面の衛生対策
価格情報
施工範囲によって変動いたしますので、お気軽にお問い合わせください。
納期
用途/実績例
医療施設や介護施設など、衛生管理が求められる環境の接触面に施工可能です。 ・病院 ・クリニック ・介護施設 ・福祉施設 ・学校 ・公共施設 ・商業施設 ・オフィス 接触頻度の高い場所の衛生管理対策として導入されています。
詳細情報
-

噴霧作業風景1
-

噴霧作業風景2
-

施工証明書sample
-
接種直後:肺炎桿菌肺炎桿菌99.9%以上の抗菌効果
-

接種直後:MRSA MRSA99.9%以上の抗菌効果
カタログ(1)
カタログをまとめてダウンロード企業情報
当社は、日本のものづくり復活、医療の発展、環境の保全に配慮し、製造事業、メディカル事業、環境科学事業の3事業部体制で活動しております。国内3拠点(福島本社、東京都新宿、神奈川県厚木)と海外1拠点(中国)になります。福島本社(TEL0243-24-8773)にご連絡頂ければ、各担当の営業社員からご連絡させて頂きます。弊社ホームページもご覧ください。 製造事業部は、大手企業から中小企業までをネットワークで繋いで、ものづくりの様々な困りごとを解決致します。デザイン、設計、試作、量産、FA、海外調達など、材料調達、小ロット、多品種、1ヶからの試作なども対応いたします。 メディカル事業部は、持続可能な医療体制構築の為に、R-SUDを筆頭に、革新的医療機器、AI関連、衛生環境改善製品のご提案し、病院経営に大きく貢献する唯一無二の製品を数多く取り扱っております。 環境科学事業部は、CO₂削減に直結する植林事業(カーボンニュートラル)、建築費高騰の中、建物を「造る時代から長く守る時代へ」転換する防水製品、環境配慮型の新電力をご案内しております。共に持続可能な社会へ。











